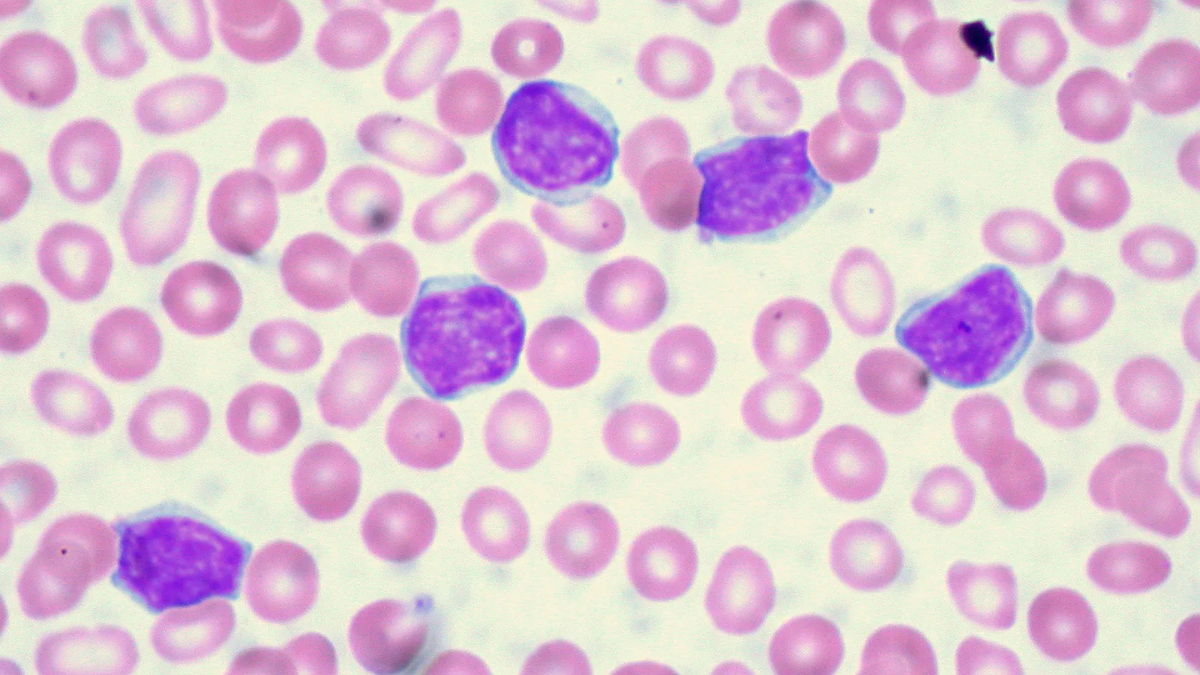
02-leukemia

In a promising step forward in the fight against acute myeloid leukaemia (AML), a cutting-edge genetic test has shown the potential to detect relapse months before symptoms appear, offering patients a crucial window to begin alternative treatment. The breakthrough has already saved at least one life and is being hailed as a possible game-changer in cancer care.
Table of Content:-
A Patient’s Journey: How Early Detection Saved a Life
Jan Leahy, a 51-year-old woman from Wimbledon, England, credits this new test with saving her life. Diagnosed with AML—a fast-progressing form of blood cancer—Leahy had been undergoing chemotherapy when her cancer stopped responding to treatment. Thanks to the experimental bone marrow test she was receiving as part of a clinical trial, doctors were able to identify signs of her cancer returning months before traditional tests could have picked it up.

This early warning allowed her care team to pivot quickly and initiate different treatments. Leahy eventually achieved remission and was prepared for a stem cell transplant that she believes would not have been possible without the head start. “Being part of this trial saved my life and gave me more treatment options,” Leahy said. “It’s amazing to see progress in how we fight this disease.”
The Science Behind the Test: Detecting Cancer’s Quiet Return
Published in The Lancet Haematology on April 28, the study that Leahy participated in focused on a highly sensitive bone marrow test capable of detecting minimal residual disease (MRD)—traces of cancer that linger even after remission. These traces often signal that a full relapse is on the horizon.
Also Read: Measles Cases Surge To 683 In Texas, Health Officials Sound Alarm
The test homes in on specific gene mutations, such as NPM1 and FLT3, which are often present in younger AML patients. By monitoring these genetic markers, doctors can spot the earliest signs of recurrence—up to three months before they would become evident through standard blood tests or physical exams.
Dr Richard Dillon of King’s College London, one of the lead researchers, emphasised the urgency of early detection in AML cases. “AML is the most aggressive blood cancer,” he said. “Detecting relapse early is critical. We hope this test becomes a routine part of care worldwide, improving survival for more patients.”
Significant Survival Gains in Clinical Trials
The clinical trial monitored 637 AML patients in remission over three years. While one group received routine follow-up care, the other was tested regularly using the new genetic method. The results were striking: those in the genetically monitored group had survival rates 50% higher than those who only received standard care.
Also Read: Climbing Craze Comes With A Catch: Experts Warn Indoor Climbing May Harm Your Lungs
According to Dr Nigel Russell from Guy’s and St Thomas’ NHS Foundation Trust, another lead author of the study, “This kind of early monitoring could be a game changer. There’s still a lot to learn about how best to treat AML, but this research offers a new strategy for keeping patients ahead of the disease.”

A New Era in AML Care?
AML is notorious for returning swiftly, often within two years of treatment. While chemotherapy remains the first line of defence, relapses have long been a major challenge. The ability to detect a return of the disease early, while a patient is still relatively healthy, could drastically alter outcomes. It allows doctors to take proactive steps before the cancer can spread and do further damage.
Though this test is not yet a universal part of leukaemia care, researchers are hopeful. With such promising results, calls are growing louder for its inclusion in standard protocols worldwide. For patients like Jan Leahy and many others battling AML, this new tool offers more than hope—it offers time. And in cancer care, that can mean everything.
Also watch this video
Read Next
Ozzy Osbourne Opens Up About Mental Struggles with Parkinson’s Before Final Black Sabbath Show
How we keep this article up to date:
We work with experts and keep a close eye on the latest in health and wellness. Whenever there is a new research or helpful information, we update our articles with accurate and useful advice.
Current Version
